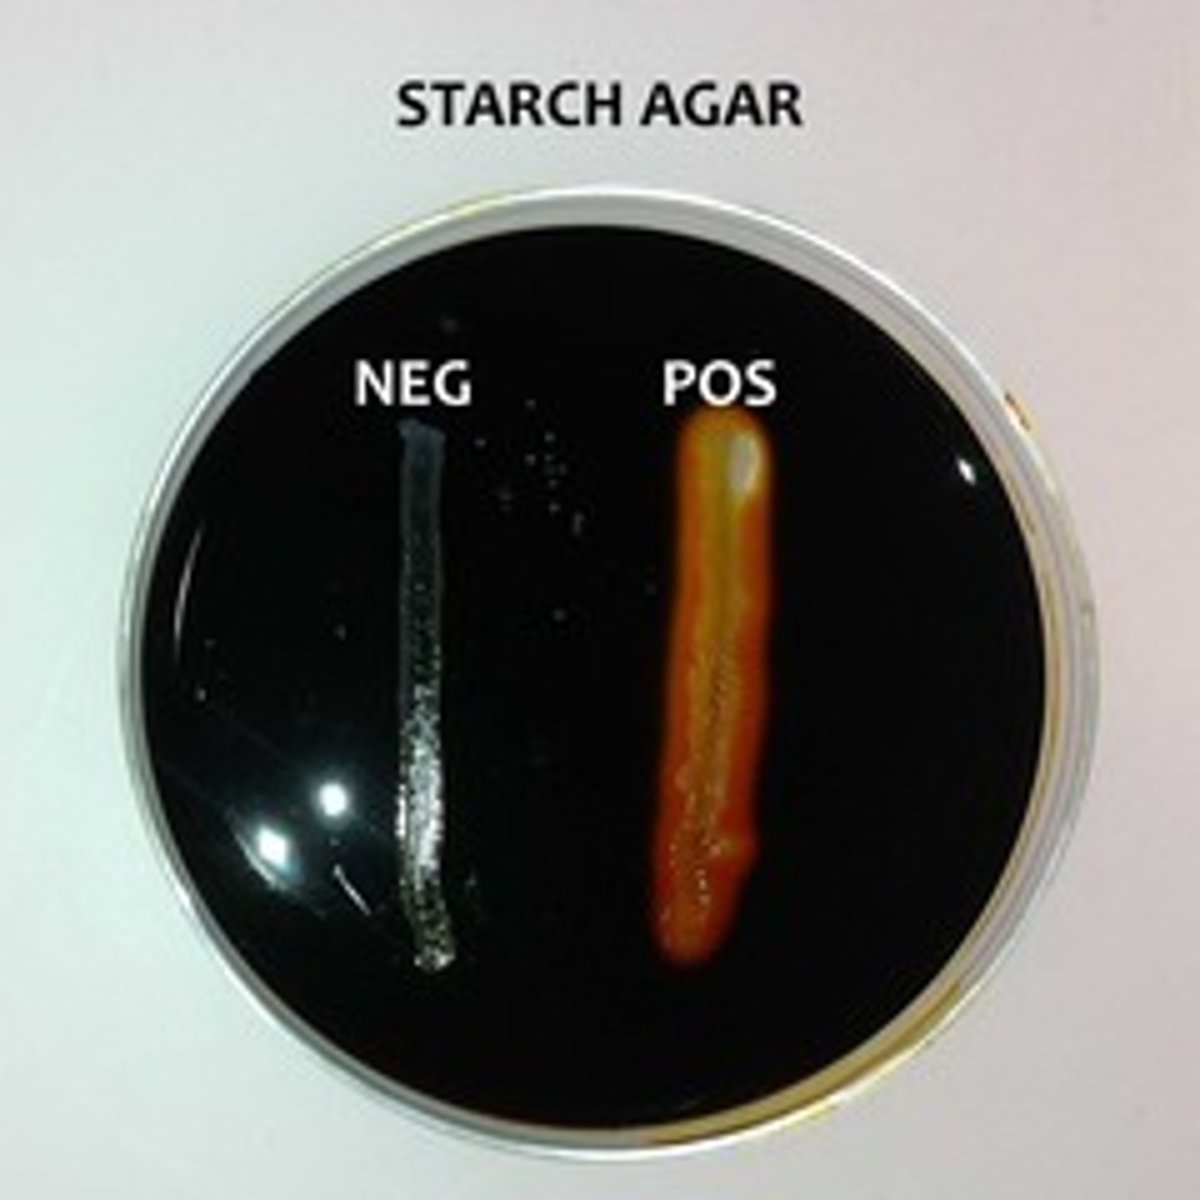
knowt flashcard image

1/24
Looks like no tags are added yet.
Name | Mastery | Learn | Test | Matching | Spaced |
|---|
No study sessions yet.
Bile esculin agar identifies
Enterococci and Group D streptococci
Coagulase
identifies staph aureus, Gram positive
Methyl red test
eschericia, salmonella, and proteus
VP test
enterobacter and serratia, bacillus
Citrate test
Enterobacter aerogenes and Salmonella typhimurium
SIM sulfur reduction
gram negative rods
Swarming motility
Proteus mirabilis
Phenylalanine test
proteus (enteriobacteriacae)
Urea
proteus
IMVIC
compares E.coli with enterobacter aerogenes
catalase test

citrate test

EMB

KOH

Methyl Red

Nitrate reduction

O/F Glucose

Oxidase

Phenylalanine test

SIM hydrogen sulfide production

SIM indole production

Motility test

Starch hydrolysis
Urea

VP test
